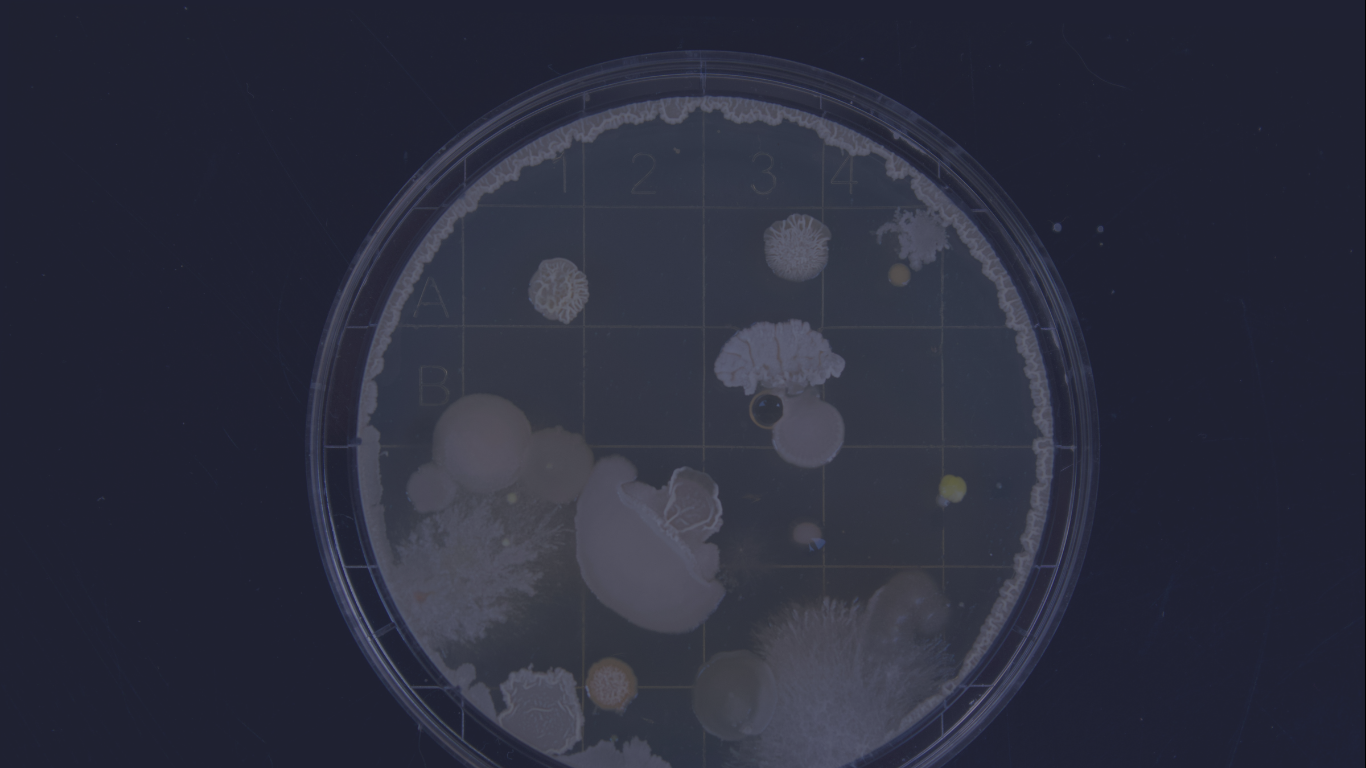
Background Heimspiel Wissenschaft

BioQuant is Heidelberg University's interdisciplinary Research Center for Quantitative Analysis of Molecular and Cellular Systems. The center is regarded as a hub for research and teaching in quantitative biology. Work at BioQuant integrates quantitative experimentation, cutting-edge technology and computing to advance an integrative understanding of the complexity of the systems studied. Such "cross-boundary" research is timely and has become necessary for answering numerous questions in biological and medical systems. And it has been part of BioQuant's mission since its inception, and the environment at BioQuant fosters such activities on campus and beyond with unsurpassed opportunities.
NEWS
All News